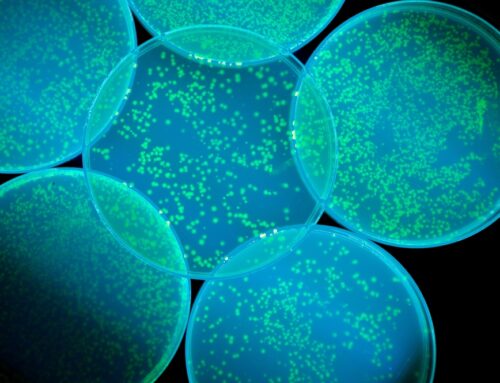
Αντιβιοτικό στην «αφάνεια» 100 φορές ισχυρότερο ενάντια στα υπερβακτήρια

Ο τρόπος ζωής μας επηρεάζει σε μεγάλο βαθμό το πόσο αποτελεσματικά μπορεί το ανοσοποιητικό μας σύστημα να μας προστατεύει από μικρόβια, ιούς και χρόνιες ασθένειες. Αντικαθιστώντας κάποιες “κακές” συνήθειες με πιο υγιεινές, μπορούμε να ενισχύσουμε τη φυσική μας άμυνα και να νιώθουμε πιο δυνατοί μέσα στην ημέρα μας.
Ας δούμε ποιοι παράγοντες το αποδυναμώνουν, και τι μπορούμε να κάνουμε εμείς για αυτό.
Δεν κοιμάστε αρκετά
Ίσως και να το έχετε ήδη παρατηρήσει αλλά όταν δεν κοιμάστε καλά, αρρωσταίνετε πιο εύκολα. Έρευνες δείχνουν ότι όσοι ξεκουράζονται επαρκώς ανταποκρίνονται πιο αποτελεσματικά στα εμβόλια και στις λοιμώξεις. Η έλλειψη ύπνου αυξάνει τα επίπεδα ορμονών του στρες και την φλεγμονή στο σώμα, επηρεάζοντας άμεσα το ανοσοποιητικό σύστημα.
Δεν κινείστε αρκετά
Η τακτική άσκηση βοηθά τον οργανισμό να πολεμήσει αποτελεσματικότερα τις λοιμώξεις. Όσοι δεν ασκούνται συστηματικά έχουν περισσότερες πιθανότητες να κρυολογήσουν σε σχέση με εκείνους που το κάνουν. Η άσκηση βελτιώνει επίσης τον ύπνο, που με τη σειρά του θα κάνει ακόμα καλύτερα τα πράγματα.
Η διατροφή σας δεν είναι αρκετά ισορροπημένη
Η υπερβολική κατανάλωση ζάχαρης καταστέλλει την ικανότητα των λευκών αιμοσφαιρίων να καταπολεμούν τα βακτήρια. Η επίδραση αυτή μπορεί να διαρκέσει αρκετές ώρες. Προτιμήστε φρούτα και λαχανικά πλούσια σε βιταμίνες C και Ε, β-καροτένιο και ψευδάργυρο, όπως μούρα, εσπεριδοειδή, ακτινίδια, σπανάκι, καρότα και γλυκοπατάτες.
Ζείτε με χρόνιο στρες
Το στρες είναι αναπόφευκτο, αλλά όταν αρχίζει να αποτελεί χρόνιο πρόβλημα, αποδυναμώνει το ανοσοποιητικό και αυξάνει τον κίνδυνο για λοιμώξεις και χρόνιες παθήσεις σε τεράστιο βαθμό. Δεν μπορούμε πάντα να απομακρύνουμε τις πηγές άγχους, μπορούμε όμως να μάθουμε να το διαχειριζόμαστε:
*Δοκιμάστε διαλογισμό ή τεχνικές χαλάρωσης
*Μειώστε τους καθημερινούς ρυθμούς και δώστε προτεραιότητα στην ξεκούραση
*Μιλήστε με φίλους ή έναν επαγγελματία ψυχικής υγείας
*Κάντε γυμναστική για εκτόνωση
Η διαχείριση του στρες μειώνει τα επίπεδα κορτιζόλης, βελτιώνει τον ύπνο και ενισχύει την αντίσταση του ανοσοποιητικού.
Νιώθετε απομονωμένοι
Η παρέα με τους άλλους ανθρώπους δεν κάνει καλό μόνο στην ψυχή, αλλά και στο ανοσοποιητικό. Τα άτομα που νιώθουν συνδεδεμένα με φίλους ή με μια κοινότητα έχουν ισχυρότερη ανοσολογική απόκριση, σύμφωνα με πολλές έρευνες. Σε μια μελέτη, πρωτοετείς φοιτητές που ένιωθαν μοναξιά είχαν πιο αδύναμη αντίδραση στο εμβόλιο της γρίπης σε σχέση με όσους είχαν καλύτερη κοινωνική ζωή.
Έχετε χάσει το χιούμορ σας
Το γέλιο είναι ίσως η πιο απλή “θεραπεία” που υπάρχει. Ναι, δεν υπερβάλλουμε. Μειώνει τις ορμόνες του στρες και ενισχύει την παραγωγή λευκών αιμοσφαιρίων, εκείνων δηλαδή που καταπολεμούν τις λοιμώξεις. Έχει παρατηρηθεί ότι και μόνο η προσμονή ενός αστείου γεγονότος μπορεί να έχει θετική επίδραση – άρα ένας καλός λόγος να αγαπήσετε τους φίλους σας που κάνουν πολλή ώρα για να πουν μια ιστορία, λέμε εμείς.
Θοδωρής Διάκος
Συντάκτης – Δημοσιογράφος